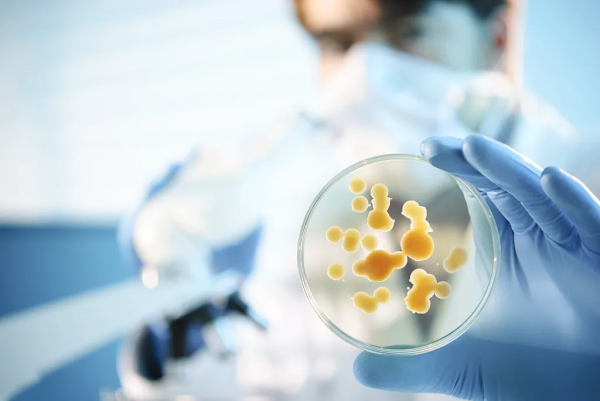
食物亂放冰箱裡，當心中毒

冰箱家家都有,但是有人說,冰箱用不好,就是毒箱!
難道這是危言聳聽嗎?
啄修修這就告訴你,食物放進冰箱真得講究!
冰箱,使用了低溫儲存食品的方法。在中國的商代就已經懂得用冰塊儲存食品了。
我們現在也發現細菌在5°~60°的環境下繁殖迅速;而在冷藏的溫度下,細菌生長就會變得緩慢。
而速凍則讓食物組織中的水分、汁液不至於流失,微生物基本不會繁殖,食品的安全會更有保證。
但是我們要記住,細菌繁殖緩慢,不代表不繁殖,或者通通死亡。
有時它們仍然會繁殖,這就是為什麼有的食用了冰箱裡面的食物會拉肚子的重要原因。
哪有人會問啄修修,我們應該如何避免這種倒黴事兒呢?
第一要知道食品的分類。
食品有熟製品(已經完成加工的熟食、如醬牛肉)、半成品(有加工環節的食品,如醃製過的肉)、生品(未加工過的,如生牛肉)。
拉開冰箱門,我們會發現,不管是冷藏室,還是冷凍室,都是分層的。我們要把熟製品放在頂層,半成品放在第二層,生品放在第三層。
而在第三層,尤其是冷藏室,還應對水果、蔬菜、蛋類、肉類進行相對獨立的擺放,避免一些細菌交叉傳播。
還有好多女性喜歡把面膜放在冰箱裡,這就更要分開儲存,否則面膜上的細菌也會弄到食物上,造成不必要的汙染。
我們要明白最優的儲存措施。
比如,冰箱門處離外界較近,所以不能存放開封的食品飲品,而是應存放包裝完好、沒開封的食物。
很多人原因把雞蛋放在開門的位置上,但有個爭議,雞蛋最好是要放在密封的容器中儲存,溫度最低20°。
冷藏室下層的溼氣較大,適合水分較多的葉類菜和水果的存放,但要在存放之前搽幹水分,更不要使用不透氣的塑膠袋封住它們。
冷藏的食物也不要放置過密,應該留下足夠的空間,讓冷空氣迴圈,這樣才能加快食物的降溫速度。
我們還要記住食物的最佳儲存期限。
此列表就是各種食材的最高儲存期限
記住食物的營養價值,一定是在最新鮮的時刻最高,口感也是最新鮮的時候最好。
所以買來的東西,最好吃的越快越好,實在吃不完才放冰箱。
最後注意冰箱消毒。冰箱並非無菌,反而是一些喜冷細菌的“溫床”,比如耶爾深菌、李斯特氏菌等。
我們在家應每月至少進行一次冰箱內膽的消毒。消毒時要斷電,把食品全都拿出,尤其要及時清理過期或者變質的食品。
冰箱清洗方法
毛細管髒堵故障的排除方法有兩種:一是用高壓氮氣結合其他方法將堵塞的毛細管的髒物吹出,毛細管吹通後,經過對製冷系統內各部件的清洗乾燥後重新進行組裝焊接將故障排除。如果毛細管堵塞嚴重,上述方法不能排除故障則採用更換毛細管的方法排除故障,分述如下:
1、用高壓氮氣吹出毛細管中的髒物:割開工藝管放液,將毛細管從乾燥過濾器上焊下,在壓縮機工藝管上接上三通修理閥,充入0.6~0.8MPa的高壓氮氣,並將毛細管伸直用氣焊碳化焰加溫,將管內的髒物碳化,在高壓氮氣作用下將毛細管內的髒物吹出。毛細管暢通後,加入四氯化碳100毫升進行充氣清洗。冷凝器的清洗可在管道清洗裝置上用四氯化碳清洗。然後更換乾燥過濾器,再充氮檢漏、抽真空、最後充灌製冷劑。
2、更換毛細管:如果採用上述方法無法將毛細管中的髒物衝出,則可連同低壓管一起更換毛細管。先用氣焊將低壓管和毛細管一起從蒸發器銅鋁接頭上卸下,在拆卸和焊接時應先用溼棉紗將銅鋁接頭包住以防高溫燒壞鋁管。
3、更換毛細管應進行流量測定,毛細管出口先不與蒸發器入口焊接,在壓縮機的吸排氣進出口分別裝修理閥和壓力錶,壓縮機運轉後,空氣從低壓修理閥吸入,待吸入壓力與外界大氣壓相等時,高壓表的指示壓力應穩定在1~1.2MPa。如壓力超過,說明流量過小,可截去一段毛細管,直至壓力合適為止。如壓力過低,說明流量過大,可將毛細管多盤幾圈以加大毛細管的阻力,或更換一根毛細管,待壓力合適後將毛細管與蒸發器的進口管焊接。
4、在焊接新毛細管時,應使插入銅鋁接頭內的長度約為4~5cm,以免焊堵。毛細管與乾燥過濾器焊接時其插入長度以2.5cm為宜,如果毛細管插入乾燥過濾器過多,離濾網太近,微小的分子篩顆粒就會進入毛細管將其堵塞。若毛細管插入過少,焊接時的雜質和分子篩顆粒便會進入毛細管,直接堵塞毛細管通道。因此毛細管插入過濾器,既不能過多也不能過少。過多或過少都會造成堵塞的危險。